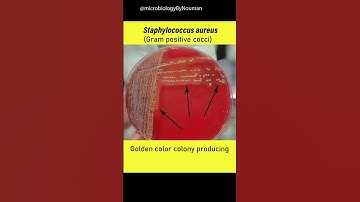
Staphylococcus aureus on Blood agar plate #shorts #youtubeshorts

⬇ DOWNLOAD NOW
Kalau muncul iklan pop-up, tutup lalu klik tombol kembali
Download lagu Staph aureus | important points | @MicrobiologyByNouman secara gratis hanya untuk keperluan promosi. Dukung artis favorit kamu dengan membeli musik original di iTunes atau platform resmi lainnya.
 Staphylococcus aureus
Staphylococcus aureus
 Learn about Staphylococcus aureus - Sketchy Medical (USMLE Step 1)
Learn about Staphylococcus aureus - Sketchy Medical (USMLE Step 1)
 Staphylococcus Aureus for the USMLE Step 1
Staphylococcus Aureus for the USMLE Step 1
 Staphylococcus Aureus
Staphylococcus Aureus
 Staphylococcus: Aureus, Epidermidis, Saprophyticus
Staphylococcus: Aureus, Epidermidis, Saprophyticus
 Chromatic Staph aureus
Chromatic Staph aureus
Staphylococcus aureus on Blood agar plate #shorts #youtubeshorts
Staphylococcus aureus on Blood agar plate #shorts #youtubeshorts
 2 Streaking for Isolation--Subcultures--Staph Aureus
2 Streaking for Isolation--Subcultures--Staph Aureus